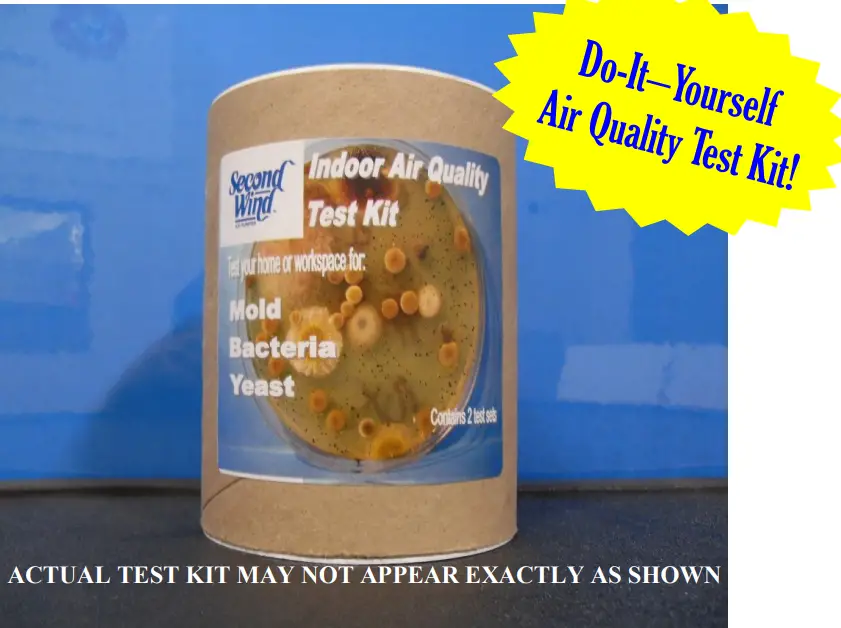
SecondWind SF102 998 Indoor Air Quality Test Kit - fig
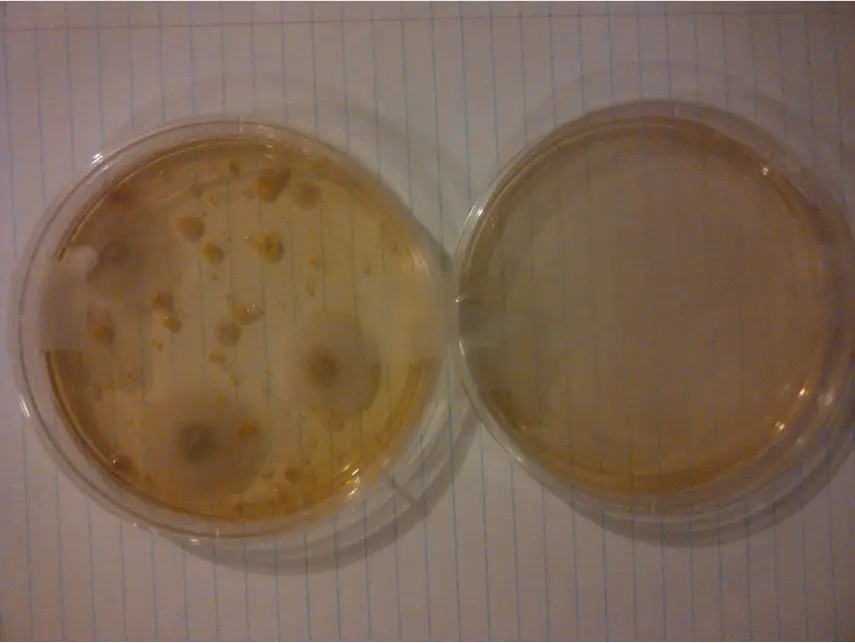
SecondWind SF102 998 Indoor Air Quality Test Kit - fig 1

SF102-998 Indoor Air Quality Test Kit
SF102-998 Indoor Air Quality Test Kit
User Manual
SF102-998 Indoor Air Quality Test Kit
CANADIAN & INTERNATIONAL SALES OFFICE
GCF Products Ltd.
400 Midwest Rd,
Toronto, ON M1P3A9
P: 888-216-9184
F: 416-757-4687
The U.S.A. DOMESTIC SALES OFFICE
General Filters Inc.
43800 Grand River Ave.
Novi, MI 48375
P: 866-476-5101
F: 248-349-2366
Indoor Air Quality Test Kit
Second Wind is pleased to introduce an Indoor Air Quality Test Kit to provide a NEW TOOL in identifying Air Quality concerns. Second Wind UV Solutions can be employed to help remedy homes that yield results showing pathogens like Mold, Bacteria and/or Yeast. After a 1 hour exposure time and a short gestation period, you can see the results of the test in the Petri dish without needing to send it away to expensive laboratories. You can discuss with your local Second Wind contractor what the best Second Wind Solution may be for your home. The results found in the Petri dish offer a representation of the microscopic pathogens that exist in the Home Air (NOTE: Viruses and Volatile Organic Compounds are not detected by the kit). If the test yields results showing mold, bacteria or yeast, discussions about the appropriate Second Wind Solution can follow.
After a 1 hour exposure time and a short gestation period, you can see the results of the test in the Petri dish without needing to send it away to expensive laboratories. You can discuss with your local Second Wind contractor what the best Second Wind Solution may be for your home. The results found in the Petri dish offer a representation of the microscopic pathogens that exist in the Home Air (NOTE: Viruses and Volatile Organic Compounds are not detected by the kit). If the test yields results showing mold, bacteria or yeast, discussions about the appropriate Second Wind Solution can follow.
Taking a photo will provide a great tool during the follow-up procedure!!!
If you choose to install a Second Wind Solution, we encourage you to perform the test again. We are confident that positive results will be seen and felt by you and your family.
Test# 1—showed the presence of mold, bacteria, and yeast in household air (Feb 2013, in SW Ontario, Canada) Test#2—after 1 week of operation of Second Wind Model# 2000
Test#2—after 1 week of operation of Second Wind Model# 2000
Tests conducted by contractor/homeowner. 1-hour exposure of media to household air. Petri Dish sealed and stored for 7 days in a dark setting with no sunlight exposure “
Indoor Ait quality Test Kit Frequently Asked Questions
- What are the Ingredients of the Second Wind IAQ Test Kit?
In the interest of safety. Second Wind searched for a safe testing system that would not harm people or house pets that may come in contact with the test media. The U.S. manufacturer of our IAQ Test Kit has commented:
We don’t have a formal statement about product safety. The reason we haven’t to this point is our products contain a lot of food grade ingredients and should not he hamlet!. especially to animals” - Does the Second Wind IAQ Test Kit detect everything In the home’s air?
The Test Kit is designed to detect Mold. Bacteria and Yeast only. It does not conform what types or breeds of any of these pathogens exist. Viruses and Volatile Organic Compounds VOCs) that may produce offensive odors are not detected by this test. - I ran the ‘Before’ Test and decided to install a Second Wind product. When I ran the ‘After’ test, I still had some growth in my Petri dish, why?
Low levels of pathogens may continue to exist after an IAQ solution like a Second Wind product is installed in the home. These levels often change from day to day. Consistent test methods and testing locations should show reductions of growths from Before to After the test. - What is the best method and location for testing?
Repeated satisfied customers and service technicians have promoted the following test plan. Please note that the units must be stored and used in an area with an ambient temperature of 18°-25°C (65°-77°F)- Find an area in the home not receiving any direct sunlight with little direct airflow – a dust-free coffee table or top of a cabinet away from windows and air vents are good examples
- Open the Petri dish and place the lid face down on the adjacent surface to the test area – you don’t want extra contamination sitting in the lid area
- Pour test media into a Petri dish
- Allow test media in Petri dish to remain undisturbed for one hour
- Cover Petri dish with supplied lid – be careful not to push lid too hard, it may damage lid
- Re-seal with supplied tape or use new to keep closed Petri dish sealed
- Put the test kit into the box that the product was shipped in and close lid
- Print test date on lid and list with homeowner’s name (if the customer wants a service technician to control)
- Examine test results in 5-6 days and follow up with homeowner and plan next steps
- Do the IAQ Test Kits have an expiry date?
Second Wind IAQ Test Kits have a useful life of 1 year from the date of manufacture when stored and used under the conditions above.

![]() Our Brands ® Last Updated: 03-2022
Our Brands ® Last Updated: 03-2022
400 Midwest Rd. Toronto, ON M1P 3A9
Canada Toll-Free: (888) 216-9184
www.generalaireiaq.ca
[email protected]![]()



















